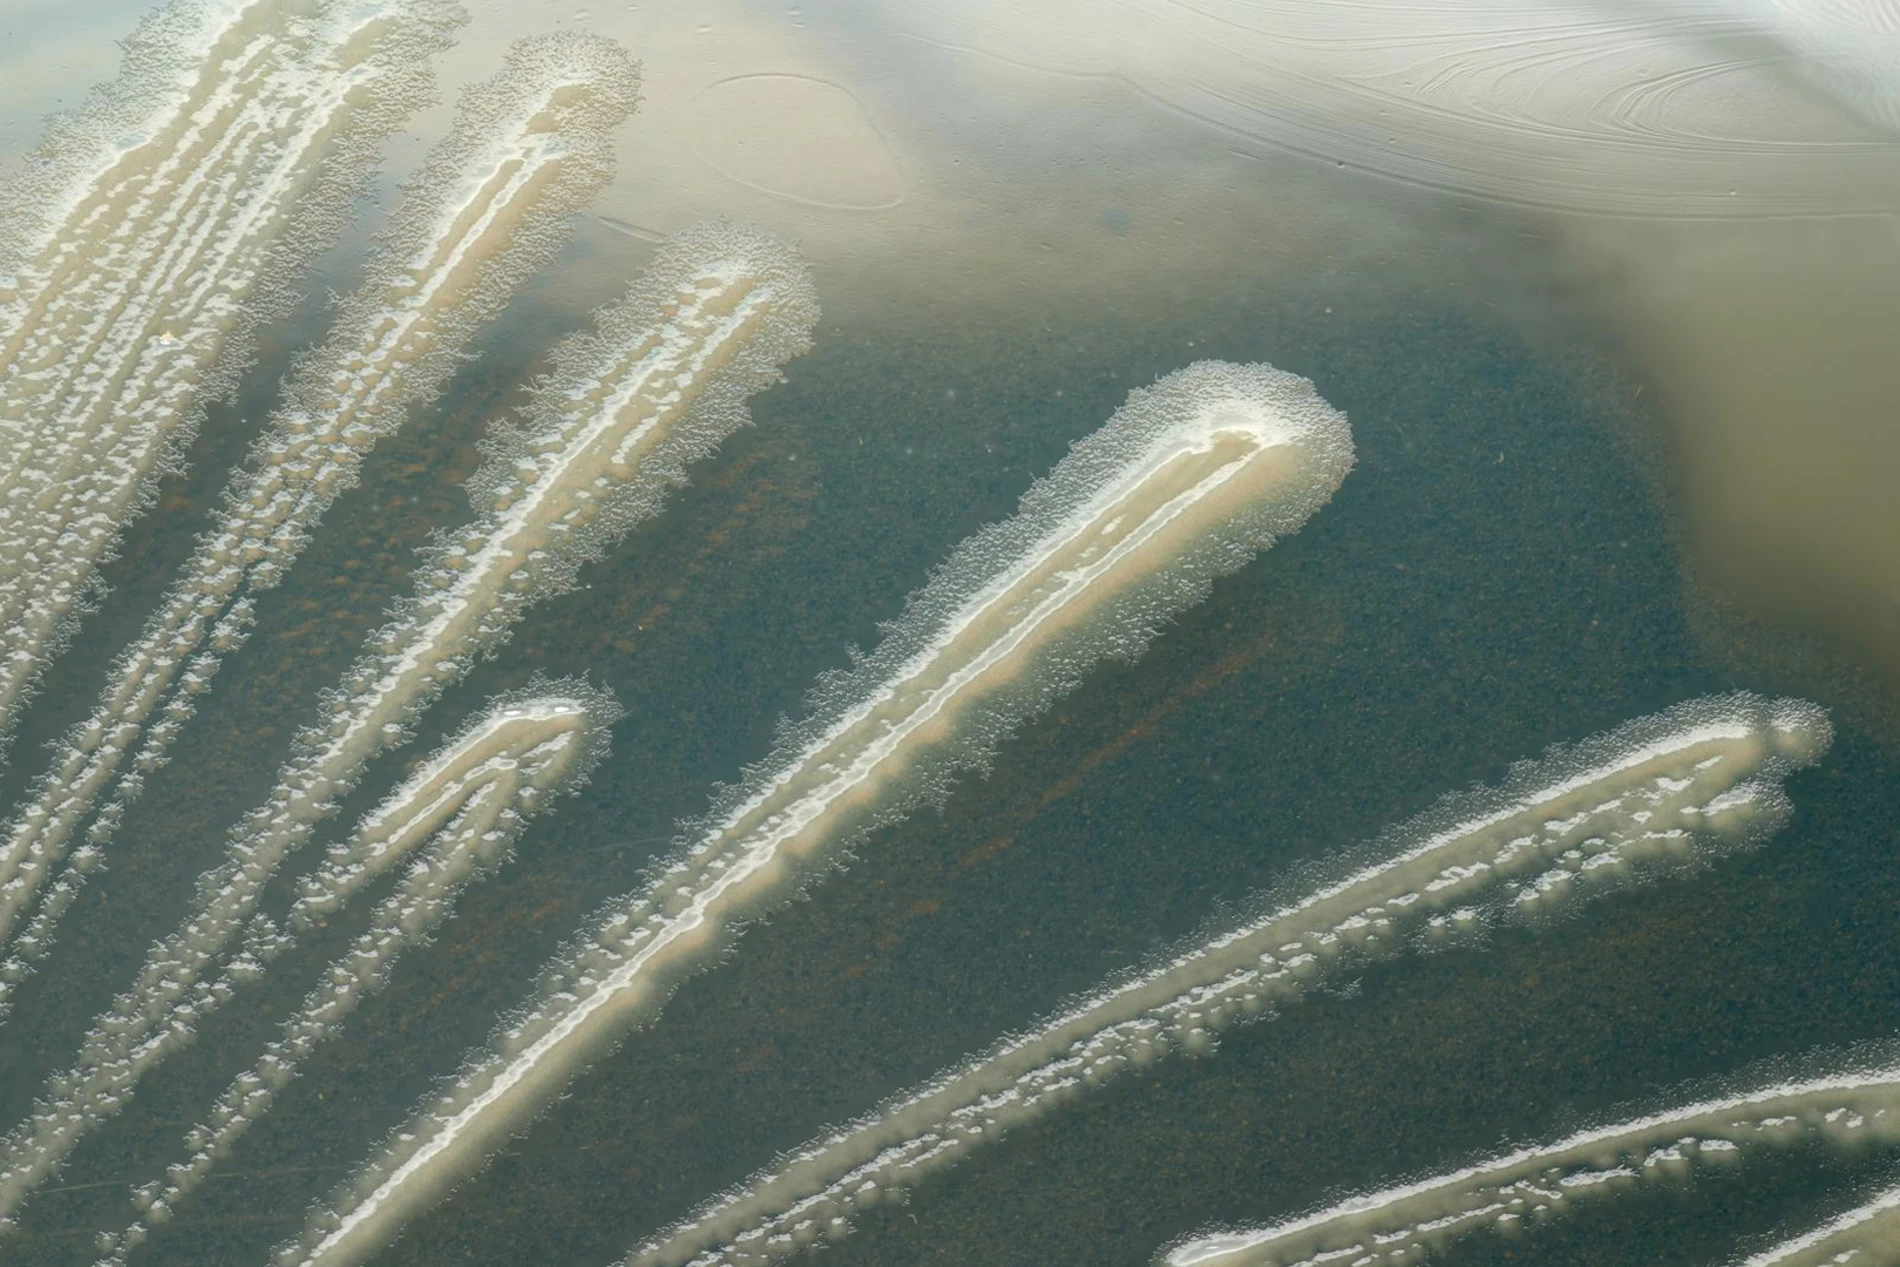
microscope microbial

Strain matters
Not all microbial biosolutions are created equal. Even within the same species, different microbial strains can behave like totally different organisms. That’s why choosing the right strain—or the right combination—is the key to making biosolutions work for your business.
We live in a microbial world
Since the first glimpse under a microscope in 1676, our understanding of microbes has expanded rapidly. Today, we know there are likely over a trillion microbial species—far outnumbering all plants and animals combined. And no two strains are exactly the same.
One species, a thousand personalities
Bacillus subtilis isn’t one thing—it’s thousands. Each strain comes with its own genetic identity and functional traits. While there are hundreds of dog breeds or cattle types globally, none match the microbial diversity found within a single species like Bacillus subtilis.

Microbes are individuals, too
Think of strains as individuals within a population: genetically unique, biochemically distinct and behaviorally different. This diversity is what makes strain selection so powerful—and so critical. How do we know which strain to pick for the right job?

Built on science. Proven in practice.
Our strain selection process is grounded in rigorous science—from precise identification and safety assessment to in vitro screening, in vivo research studies and real-world trials. Only strains that prove their value at every step make it into our solutions.
Why strain selection matters
Every microbial strain is unique. Some produce enzymes. Some support gut balance. Others don’t do much at all. The differences are real—and they matter. Here’s why strain selection is critical to getting the results you need.
Enzyme production varies wildly
Some Bacillus subtilis strains produce powerful cellulases and xylanases. Others don’t. Strain-specific enzyme activity makes all the difference when targeting fiber breakdown and nutrient release.

Microbial interaction isn’t universal
When tested against Salmonella heidelberg, some strains stopped it cold. Others didn’t touch it. The ability to support microbial balance is strain-dependent—and choosing wrong costs performance.
Genetics define function
In one study, 17 B. subtilis strains showed up to 66% genetic divergence in key traits like metabolism and antimicrobial activity. That means one strain may support gut balance—another may do nothing.

The difference is real
Below charts show a comparison of different strains of Bacillus subtilis and Bacillus amyloliquefaciens in terms of their enzymatic activity. If you are looking for a high-performing probiotic, which strain would you choose?
No single strain solves it all
Different challenges call for different solutions. That’s why success depends on selecting the right strain—or the right combination—for a specific goal. When well-matched, strains can help address some of the biggest challenges we face.
Schedule a call with our technical experts
Curious to learn more about strain-to-strain differences and how Novonesis scientists select the best strains? Reach out. We are just a call away.
One more step…
To complete the get in touch form or sign up, please click on the button below to enable cookies.
The information provided herein is for general information purposes only. All information is provided in good faith. Statements made in this document may fall under various jurisdictions dependent on geographical region. Claims may differ based on regional regulations. There is no warranty being extended and no liability whatsoever (including without limitation, any direct or indirect damages for lost profits or business interruption) is accepted as to its accuracy, completeness, correctness, non-infringement, merchantability or fitness for a particular purpose. The product(s) may be covered by pending or issued patents, registered or unregistered trademarks, or similar intellectual property rights.